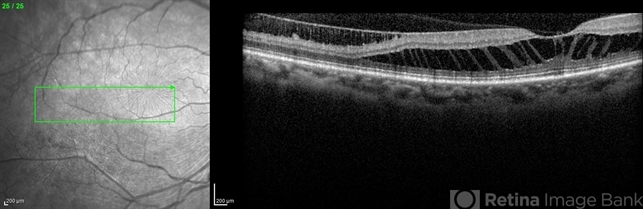
file

-
 By Niloofar Piri, MD
By Niloofar Piri, MD
SSM Health Group, St Louis University
Co-author(s): Charles C Barr, University of Louisville - Uploaded on Mar 13, 2015.
- Last modified by Caroline Bozell on Jul 10, 2015.
- Image of the week
-
Jul 12, 2015
View all images of the week - Rating
- Appears in
- Imaging
- Condition/keywords
- retinoschisis, high myopia
- Photographer
- Niloofar Piri, MD
- Imaging device
- Heidelberg Spectralis
- Description
- Infrared and HD-OCT of the right eye in a 55-year-old African American female with high myopia (more than -6.00 D), BCVA: 20/25 OU Cartwheel appearance of the fovea in the infrared imaging is visible. HD- OCT demonstartes schisis in different layers of the retina (both NFL and OPL; notice stretching of the Muller cells); VMT is also present . Outer retinal layers are preserved which explains the good vision . She had the same findings in OS.

Initializing download.
Initializing download.









---thumb.jpg/image-square;max$79,0.ImageHandler)
